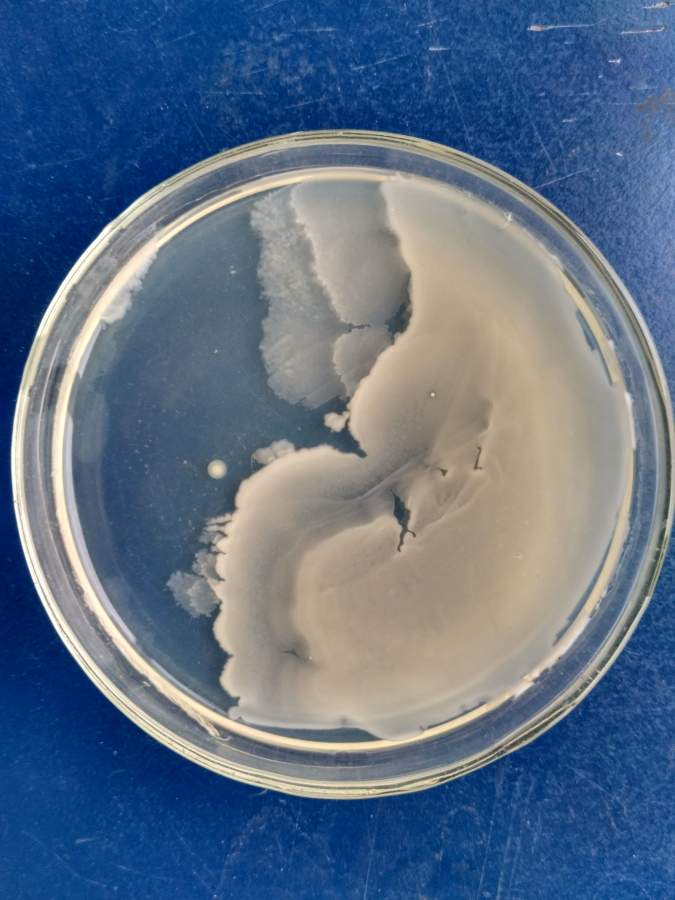
细菌涂板现象
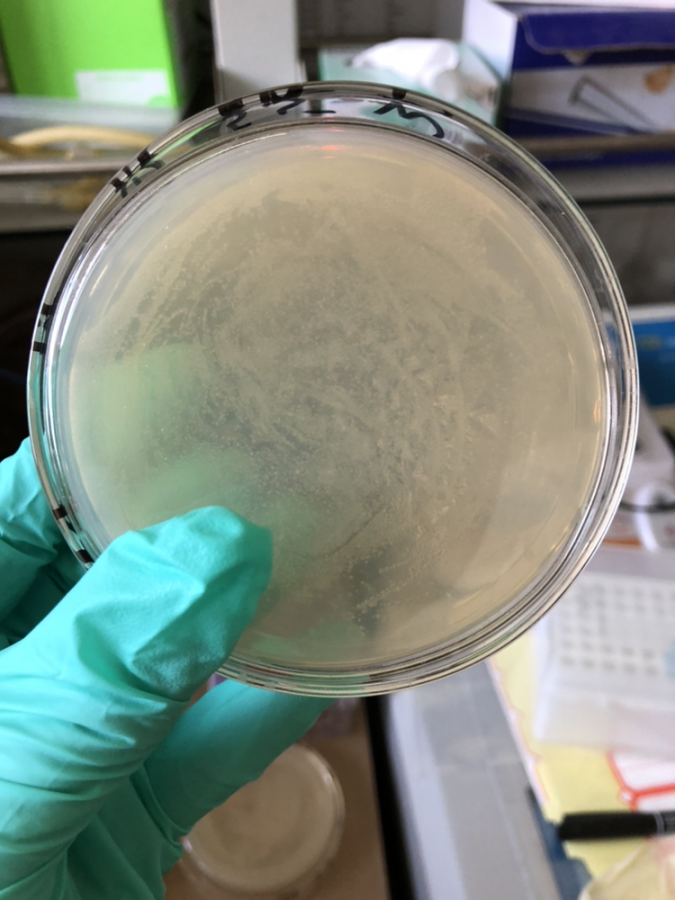
细菌涂布

细菌涂板

论坛
图片尺寸2592x1944
对大肠杆菌涂板
图片尺寸624x832
【植·实习】实习塑能,实践成长,青春向未来(二)_实验_动检_问题
图片尺寸1080x1473
细菌涂板现象
图片尺寸675x900
两天后,唇膏的培养皿中已经可以看到很多细菌了.
图片尺寸731x680
连接转化涂板出现左边情况的原因
图片尺寸1080x1439
疾控话健康细菌那些事儿金黄色葡萄球菌
图片尺寸1080x1439
细菌涂布
图片尺寸675x900
武汉云克隆科技股份有限公司
图片尺寸702x527
菌落培养怎么涂板
图片尺寸433x323
luyor3430rb检查细菌或细胞培养物的gfp表达
图片尺寸668x501
显色平板~ 真菌787878
图片尺寸1080x1439
用离心机分离细菌的方法
图片尺寸370x220
第一,银离子能干扰细菌细胞壁的合成.
图片尺寸720x540
眉县妇幼保健医院_保温装饰一体板|uv内墙装饰板|真石漆一体板|防火
图片尺寸3840x2592
微生物纯培养验证 首先配制细菌,丝状真菌易生长的pda培养基制成平板
图片尺寸600x399
粘质沙雷氏菌条纹板
图片尺寸1200x797
讨论细菌转化时热休克的作用(结果update)
图片尺寸640x617
ha,se-ha,sr-ha,zn-ha和se/sr/zn-ha浸提液与细菌共培养24小时的抗菌
图片尺寸618x451
并将其逐步杀灭的一种长期杀菌作用;以生活环境中生息的细菌为对象
图片尺寸500x375